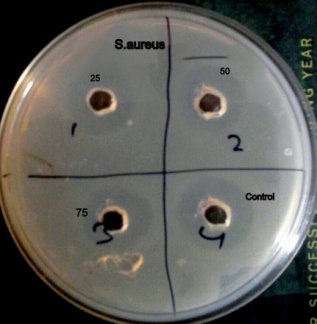

1Department of Chemistry, SHUATS University, Allahabad, India, 2Department of Pharmaceutical Sciences, SHUATS University, Allahabad, India, 3ICAR-NAARM, Hyderabad
Email: amit.chattree@shiats.edu.in
Received: 23 May 2018, Revised and Accepted: 01 Aug 2018
ABSTRACT
Objective: In the present research work silver nanoparticles were synthesized using the flower extract of Chrysanthemum coronarium and their in-vitro antibacterial activity was evaluated against both the gram-positive S. aureus and gram-negative bacteria E. coli. The flower extract acted both as a reducing as well as a capping agent.
Methods: Silver nanoparticles were verified using various spectroanalytical techniques such as visible ultraviolet spectroscopy, zeta potential, fourier transform infrared spectroscopy and particle size analyser. The antibacterial activity was evaluated against both the gram-positive bacteria S. aureus and gram-negative bacteria E. coli using the agar well diffusion method.
Results: The silver nanoparticles synthesized were confirmed by the visual colour change. The ultraviolet, visible spectroscopy showed a surface plasmon resonance at 430 nm. Zetapotential was found to be around-15.6mV where the negative value indicated that the synthesized silver nanoparticles are stable. Fourier transform infrared spectroscopy showed the functional groups responsible for the stabilization of the nanoparticles. Particle size analyser showed that the size of the nanoparticles ranged from 5-50 nm. The antibacterial activity of the silver nanoparticles which was performed against S. aureus and E. coli showed good inhibition against both the bacteria. Better antibacterial activity was found for E. coli in comparison to S. aureus as the zone of inhibition for E. coli was found to be at 12 mm at 50ug/ml whereas the zone of inhibition against S. aureus was found to be at 10 mm.
Conclusion: The silver nanoparticles were successfully synthesized using a green approach and can be used as a potential resource for therapeutic purpose.
Keywords: Antibacterial activity, Silver nanoparticles, Chrysanthemum coronarium, Flower extract, Gram-positive and gram-negative bacteria
© 2018 The Authors. Published by Innovare Academic Sciences Pvt Ltd. This is an open access article under the CC BY license (http://creativecommons.org/licenses/by/4.0/)
DOI: http://dx.doi.org/10.22159/ijap.2018v10i5.27492
Nanoparticles exhibit completely new or improved properties which is based on the specific characteristics such as size, shape and orientation [1]. Nobel metal nanoparticles are being used in the broad range of applications in the field of biology, medicine, physics, chemistry and material science [2]. Synthesis of nanoparticles using plants has proven to be a better method due to the slower kinetics and better manipulation on control over crystal growth and their stabilization [3]. Synthesis of nanoparticles using plants are found to be advantageous over other biological processes such as the use of fungi, bacteria etc as it helps in the elimination of the elaborate process of maintaining the cell culture. Green synthesis of metal nanoparticles has received considerable attention because of its numerous benefits over other chemical and physical methods. The biomolecules present in the plant extract such as enzymes, proteins, flavonoids, terpenoids and cofactors acted as both reducing and capping agent [4]. Nanoparticles attract more researchers for future developments in the area of medicine, healthcare and agriculture due to their diverse, remarkable and captivating range of biological applications [5]. These procedures are eco-friendly and cost-effective and has gained a lot of attention owing to the instinctive features such as the usage of natural resources, rapidness, ecofriendliness and benignancy. Chrysanthemum coronarium is a plant of Asteraceae family which contains various bioactive compounds that are used for the treatment of various diseases. It has medicinal properties as the leaves are expectorant and stomachic while the flowers are stomachic [6].
Sesquiterpene lactones (cumambrin and dihydrocumambrin) and the essential oils of the flower heads have been evaluated for their activity against the insects, nematodes, and plant fungal pathogens [7]. The sesquiterpene lactones which were present in the flower extract of Chrysanthemum coronarium have a strong in vitro cytotoxic activity against A549, PC-3, and HCT-15 cell lines and in vitro growth inhibitory activity with the sulforhodamine B assay [8]. The synthesis of silver nanoparticles using Chrysanthemum coronarium could enhance antibacterial activity against both the gram positive and gram negative bacteria ie S. aureus and E. coli. Literature reveals that there are no reports available for the synthesis of nanoparticles using the aqueous extract of Chrysanthemum coronarium flowers. Therefore the objective of the present study was to synthesize and characterize silver nanoparticles using the flower extract of Chrysanthemum coronarium and to determine its antibacterial activity.
Chemicals and reagants
Analytical grade AgNO3 was purchased from Sigma Aldrich. Double distilled water was used throughout the experiment. Ampicillin was taken as a control.
Preparation of aqueous flower extract
Flowers of C. coronarium were collected during the flowering stage in Janruary 2017. Voucher specimens were deposited in the herbarium of the Department of Horticulture Shuats University, Allahabad. Dried C. coronarium flowers were washed properly with distilled water to remove dirt and soil. Next, 20 grams of flowers were immersed in 300 ml boiling distilled water for 10 min and further filtered. The cooled filtrate obtained was stored at 4 °C for further use.
Biosynthesis of silver nanoparticles
50 ml of AgNO3 (2 mmol/l) aqueous solution was reacted with 50 ml of the obtained extract solution in a flask with stirring for 30 min and then continued stirring for 24 h at room temperature. The particles were then purified by centrifugation at the speed of 15000 rpm. To remove excess silver ions, the silver colloids were washed at least three times with deionized water. It was then lyophilized and stored in screw-capped vials under ambient conditions for further characterization and application [9]. The techniques used for the characterization of the silver nanoparticles were visible ultraviolet spectroscopy, zeta potential, fourier transform infrared spectroscopy and particle size analyser.
Characterization of the silver nanoparticles
Ultraviolet-visible spectroscopy of the silver nanoparticles
The formation of silver nanoparticles was determined by measuring the UV-visible spectrum in the wavelength ranging from 300-800 nm using a UV–visible spectrophotometer Shimadzu UV-3600 plus where double distilled water was used as a reference [10].
FTIR analysis of the silver nanoparticles
FTIR analysis was done using Perkin Elmer in the wavelength ranging from 4000-450 cm-1 in order to classify the biomolecules that were present in Chrysanthemum coronarium flower extracts which behaved as a capping agent and were responsible for the reduction and the stabilization of the nanoparticles [11]. Particle size analysis and zeta potential were estimated using Malvern instrument.
Antibacterial activity of AgNps
The silver nanoparticles synthesized using Chrysanthemum coronarium were tested for antimicrobial activity using agar well diffusion method against different pathogenic microorganisms such as E. coli and S. aureus. The pure cultures of bacteria were subcultured on MHA. Each strain was swabbed uniformly on to the individual plates using sterile cotton swabs. Wells of 8 mm diameter were made on nutrient agar plates using a gel puncture. Using a micropipette different concentrations 25, 50 and 75 µg/ml of nanoparticle solution was poured on to each well on all the plates. Ampicillin was taken as a control. After incubation at 37 ᵒC for 24 h, the diameter of zone of inhibition was measured in millimeter and was recorded as mean±SD of the triplicate experiments.
Silver nanoparticles were synthesized using the flower extract of Chrysanthemum coronarium which belongs to the family of Asteraceae. The colour change in the reaction mixture turned from light yellow to dark brown. Similar results were obtained in previous studies where A. vasica leaf extract was exposed to silver ion reaction mixture and turned to yellowish brown and then to dark brown in colour [12]. Silver has long been recognized as having an inhibitory effect towards many bacterial strains and microorganisms [13]. The biomolecules which were present in the plant extracts acted as a reducing agent in the conversion of silver ions in to AgNPs. Confirmation of the AgNPs synthesis was further done by UV-visible spectrophotometer Shimadzu UV-3600 plus where double distilled water was used as a reference. The surface plasmon resonance band appeared at 430 nm. In the case of synthesis of nanoparticles from the leaf extract of Aegle marmelos the spectroscopic band of silver nanoparicles solution was found to be close to 450 nm which strongly confirms the synthesis of silver nanoparticles. This absorption depends strongly on the particle size, chemical surrounding and dielectric medium [14]. Silver nanoparticles synthesized using C. coronarium showed a zeta potential of-15.6mV where the negative value indicated the coordination of anionic stabilizing agent. Negatively charged surfaces of silver nanoparticles helps in the prevention of aggregation of nanoparticles and helps in the control of shapes and sizes. The particle size analyzer showed that the silver nanoparticle ranged from 5-50 nm. Similar reports were observed using lantana camara flower extract where the particle size distribution of the formed silver nanoparticles showed a mean particle size of 62.8 nm. [15]. FTIR spectrum of silver nanoparticles was recorded using Perkin Elmer spectro-photometer at room temperature by potassium bromide pellet method. The pellet was kept in the IR path and the spectrum was measured in the range 400-4000 cm-1. They were studied to identify the possible biomolecules responsible as capping and reducing agent for the silver nanoparticles synthesized by the extract. The intense band at 3425.72 cm-1is due to the OH stretching mode and 2921 cm-1 is due to the aldehydic C-H stretching mode. The peak at 1345.1 cm-1 is due to the C=O or O-C stretching of esters and the peak at 1626.71 cm-1. is due to the N-H bending of amines. The peak at 1109 cm-1 is due to the C-N stretching of the amines. The possible functional groups involved in the reduction of silver ions having the absorbance peak at 3263.56 cm are predicted for alcohols and phenols. The peak at 2320 cm is treated as a nitrile group. The peak at 1631.78 cm is treated as aldehydes and ketones and 1022.27 cm-1 as the carboxylic acid or ethers [16]. The antibacterial activity showed the zone of inhibition against both the gram positive and gram-negative bacteria. The zone of inhibition against S. aureus was found to be at 10 mm and E. coli was found to be at 12 mm at 50 ug/ml. Similar results were reported in a research where the silver nanoparticles were synthesized using pomegranate juice extract and it was observed that the gram-negative bacteria E. coli showed a larger zone of inhibition ie 14 mm in comparison to the gram-positive bacteria S. aureus, which showed a zone of inhibition of 12 mm at 50ug/ml, this may be due to the variation in the cell wall composition [17]. The synthesized silver nanoparticle using Simaroubaglauca against pathogenic bacteria showed a better antibacterial activity against the gram-negative bacteria Escherichia coli and it was suggested that the effect would be size and dose-dependent [18]. The cell wall of the gram-positive bacteria is composed of a thick peptidoglycan layer consisting of a linear polysaccharide chains cross-linked by the short peptides, thus forming a more rigid structure leading to a difficult penetration of silver nanoparticles, while in gram-negative bacteria the cell wall possesses thin peptidoglycan layer [19].
Due to the structural difference in the composition of the cell walls of gram positive and gram negative bacteria silver nanoparticles have significantly less effect on the growth of the gram-positive bacteria. Silver nanoparticles are considered to have a slow release source of Ag ions, which interacts with sulfur-containing proteins present in the bacterial cell membrane as well as with phosphorus-containing compounds like DNA [20].
Silver nanoparticles attach to the surface of the bacterial cell membrane via interacting with the sulphur containing proteins, disturbing permeability and respiration functions of the cell, resulting in the cell death. The action of the silver nanoparticles on the bacteria was also due to the interaction with the thiol group compounds found in the respiratory enzymes of the bacterial cells thus inhibiting the respiration process in bacteria [21]. Small nanoparticles have a large surface area for interaction with bacteria, as compared to the bigger particles due to the greater antibacterial activity [22].

Fig. 1: Visual colour change of the synthesized silver nanoparticle

Fig. 2: SPR spectra of AgNPs synthesized using C. coronarium extract

Fig. 3: Zeta potential of the synthesized silver nanoparticle

Fig. 4: FTIR spectrum of the synthesized silver nanoparticle

Fig. 5: Particle size analyzer of the synthesized silver nanoparticle
A E. coli B S. aureus
Fig. 6: Antibacterial activity represented by a zone of inhibition
Table 1
| Concentration (ug/ml) mean±sd | Zone of inhibition (mm) |
| S. aureus | |
25 50 75 Control |
7±0.35 10±0.28 14±0.67 6±0.04 |
Silver nanoparticles were successfully synthesized using the flower extract of Chrysanthemum coronarium which belonged to the family of Asteraceae. It played an important role as a reducing and a stabilizing agent and also lead to the reduction in the cost of the production. Characterization of the biosynthesized silver nanoparticles was confirmed by the Ultraviolet-visible spectroscopy, particle size analyzer, zeta potential and fourier transform infrared spectroscopy. Silver nanoparticles played a profound role in the field of biology and medicine due to their attractive physiochemical properties. Silver nanoparticles demonstrated excellent antibacterial activity against both the gram-positive and gram-negative bacteria. Hence it can be concluded that an eco-friendly, cost-effective and a simple approach was used for the synthesis of the silver nanoparticles which showed an effective antimicrobial activity and can be used as a therapeutic drug to inhibit the growth of the bacterial pathogens such as E. coli and S. aureus.
All the author have contributed equally
Declared none
Sadowski Z. Biosynthesis and application of silver and gold nanoparticles. Wrodaw. University Technol 2010;1:67-71.
Wang J, Wang Z. Synthesis of flower-like CuO nanostructures via a simple hydrolysis route. Mater Lett 2007;61:41-9.
Sharma KV, Yngard AR, Lin Y. Silver nanoparticles: green synthesis and their antimicrobial activities. Adv Colloid Interface Sci 2009;145:83-96.
Ingale GA, Chaudhari NA. Biogenic synthesis of nanoparticles and potential applications. an eco-friendly approach. J Nanomed Nanotechnol 2013;4:1-7.
Ahmad N, Sharad B, Ali SS, Dutta R. Photofabrication of bio-induced silver nanoparticles for the biomedical applications. Int J Nanomed 2015;10:7019-30.
Bar-Eyal M, Sharon E, Spiegel Y. Nematicidal activity of Chrysanthemum coronarium. Eur J Plant Pathol 2006;114:427-33.
Alvarez Castellanos PP, Bishop CD, Pascual P, Maria J. Antifungal activity of the essential oil of flower heads of garland Chrysanthemum coronarium against agricultural pathogens. Phytochemistry 2001;57:99-102.
Lee DK, Park HK, Ha JT, Han SH, Yang SM. Isolation of pyrethrosin derivatives from the of Chrysanthemum coronarium L. Agric Chem Biotechnol 2003;46:76-9.
Yan H, Zhiyun UD, Jia QH, Zhikai T, Zheng Xi, Zhang K, et al. Green synthesis of silver nanoparticles by Chrysanthemum morifolium Ramat extract and their application in the clinical ultrasound gel. Int J Nanomed 2013;8:1809-15.
Anthony E, Sathiavelu M, Arunachalam S. Synthesis of silver nanoparticles from the medicinal plant Bauhinia acuminata and Biophytum sensitivum-a compartitive study of its biological activities with plant extract. Int J Appl Pharm 2017;9:22-9.
Menon S, Agarwal H, Kumar RS, Venkat kumar S. Green synthesis of silver nanoparticles using medicinal plant Acalypha indica leaf extracts and its application as an antioxidant and antimicrobial agent against foodborne pathogens. Int J Appl Pharm 2017;9:42-50.
Bhumi G, Rao G, Savithramma N. Green synthesis of silver nanoparticles from the leaf extract of Adhatoda vasica nees and assessment of its antibacterial activity. Asian J Pharm Clin Res 2015;8:42-50.
Jiang H, Manolache S, Wong LCA, Denes SF. Plasma–enhanced deposition of silver nanoparticles on to polymer and metal surfaces for the generation of antimicrobial characteristics. J Appl Polym Sci 2004;93:1411-22.
Patel S, Sivaraj R, Rajiv P, Venckatesh R, Seenivasan R. Green synthesis of silver nanoparticles from the leaf extract of Aegle marmelos and evaluation of its antibacterial activity. Int J Pharm Pharm Sci 2015;7:169-73.
Fatimah Is, Indrani N. Silver nanoparticles synthesized using lanta camara flower extract by reflux, microwave and ultrasound methods. Chem J Moldova 2018;13:1857-27.
Ali AZ, Yahya R, Sekaran DS, Puteh R. Green synthesis of silver nanoparticles using the apple extract and its antibacterial properties. Adv Mater Sci Eng 2016;1-6. http://dx.doi.org/ 10.1155/2016/4102196
Ibrahim HM, Ibrahiem AA, Dalloul TR. Biosynthesis of silver nanoparticles using pomegranate juice extract and its antibacterial activity. Int J Appl Sci Biotechnol 2016;4:254-8.
Chandrappa CP, Chandrasekar N, Govinappa M, Shanbhag Chaitra, Singh KU, Masarghal J. Antibacterial activity of synthesized silver nanoparticles by simaroubaglauca against pathogenic bacteria. Int J Curr Pharm Res 2017;9:20-2.
Shrivastava S, Bera T, Roy A, Singh G, Ramachandrarao P, Dash D. Characterization of enhanced antibacterial effects of novel silver nanoparticles. Nanotechnology 2007;18:103-12.
Rinna A, Magdolenova Z, Hudecova A, Kruzewski M, Refsnes M, Dusinska M. Mutagenesis 2015;30:59-66.
Li RW, Xie BX, Shi SQ, Zeng YH, Ou-yang SY, Chen BY. Antibacterial activity and mechanism of silver nanoparticles on Escherichia coli. Appl Microbiol Biotechnol 2010;85:1115-22.
Mata R, Bhaskaran A, Sadras RS. Green-synthesized gold nanoparticles from Plumeria alba flower extract to aument catalytic degradation of organic dyes and inhibit bacterial growth. Particuology 2015;24:78-86.